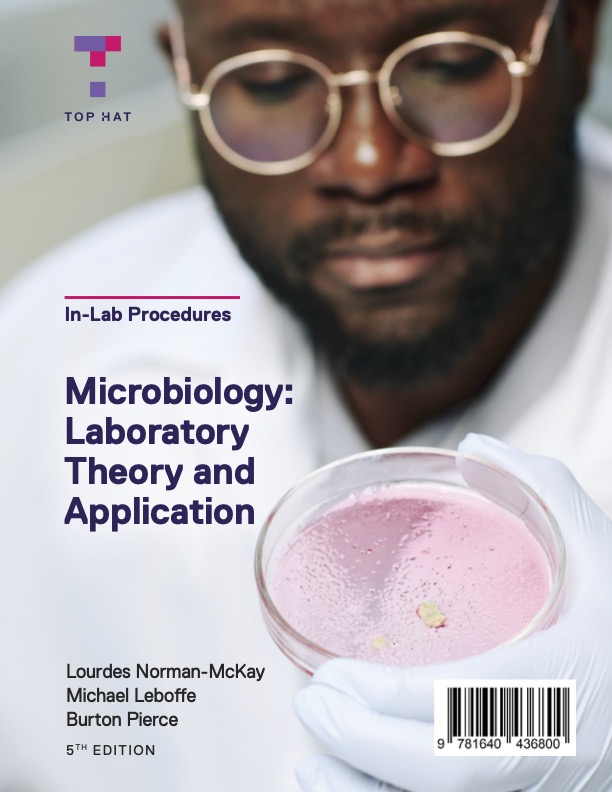

As the lead author for Canada's leading textbook on Federal Income Taxation, "Canadian Tax Principles," I can truly appreciate and attest to the importance of the editorial and related management function that is at the heart of any successful publication. You can, from an author perspective, possess the highest quality skills and innovative abilities to create a masterful textbook but, in today's world, you quickly learn that it is simply not enough. An editorialist like Suzanne, who is at the top of her game, helps navigate the often-time complexities of the publication world and provides experience, expertise, guidance, direction, including putting out fires before they are out of control, in ensuring the ultimate timely production of a publication of the absolute highest quality. These attributes underscore the critical role that Suzanne Simpson of the Simpson Editorial Group plays that are instrumental to each and every annual revision of this textbook. I have been truly fortunate to work alongside Suzanne during this, sometimes grueling, process.
-Gary Donell